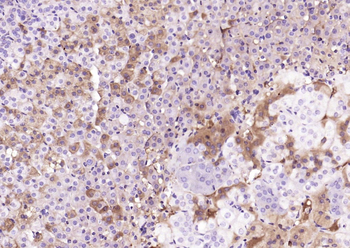
SEC14L1 Rabbit Polyclonal Antibody

You have no items in your shopping cart.
Cart summary
Item 1 of 1
SEC14L1 Antibody
Catalog Number: orb1315073
Product Properties
| Catalog Number | orb1315073 |
|---|---|
| Category | Antibodies |
| Description | Mouse monoclonal antibody to SEC14L1 |
| Target | SEC14L1 |
| Clonality | Monoclonal |
| Species/Host | Mouse |
| Isotype | IgG1 |
| Conjugation | Unconjugated |
| Reactivity | Human, Mouse, Rat |
| Immunogen | Full length human recombinant protein of human SEC14L1 (NP_002994) produced in HEK293T cell. |
| UniProt ID | Q92503 |
| Tested applications | IHC, WB |
| Dilution range | WB 1:2000, IHC 1:150 |
| Antibody Type | Primary Antibody |
| Clone Number | OTI3A6 |
| Storage | Maintain refrigerated at 2-8°C for up to 2 weeks. For long term storage store at -20°C in small aliquots to prevent freeze-thaw cycles. |
| Note | For research use only |
| NCBI | NM_003003 |
Images

Western blot analysis of HEK293T cells were transfected with the pCMV6-ENTRY control ( Left lane) or pCMV6-ENTRY SEC14L1 ( Right lane) using SEC14L1 antibody
Similar Products
SEC14L1 Rabbit Polyclonal Antibody [orb704171]
IF, IHC-Fr, IHC-P
Human
Mouse, Rat
Rabbit
Polyclonal
Unconjugated
50 μl, 100 μl, 200 μlSEC14L1 Rabbit Polyclonal Antibody [orb586275]
WB
Bovine, Canine, Equine, Guinea pig, Mouse, Rabbit, Rat
Human
Rabbit
Polyclonal
Unconjugated
100 μlSEC14L1 Rabbit Polyclonal Antibody (AP) [orb965255]
IHC-Fr, IHC-P
Human
Mouse, Rat
Rabbit
Polyclonal
AP
100 μl
Reviews
SEC14L1 Antibody (orb1315073)
Based on 0 reviews
Participating in our Biorbyt product reviews program enables you to support fellow scientists by sharing your firsthand experience with our products.
Login to Submit a Review